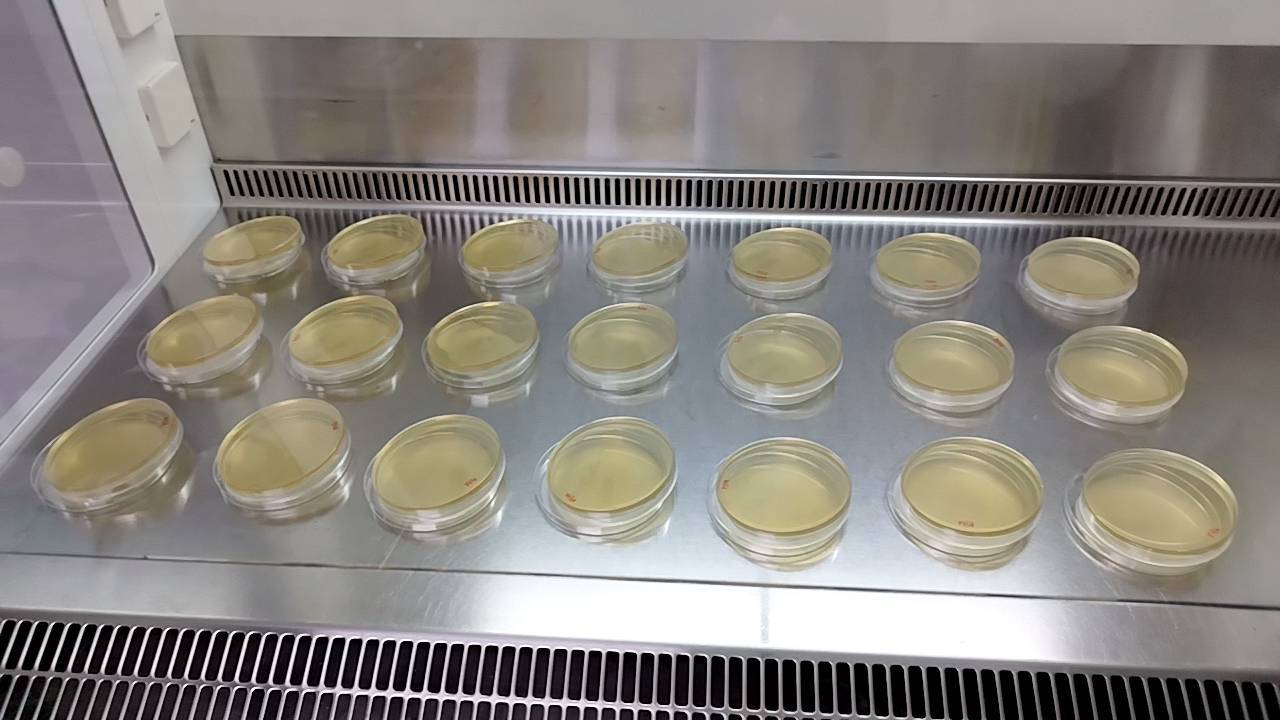

“การศึกษาสมุนไพรที่มีผลกระทบต่อสุขภาพ” เป็นประเด็นที่ได้รับความสนใจมากในปัจจุบัน และมีการศึกษาต่อยอด เพื่อให้การใช้สมุนไพรเพื่อการพึ่งพาตนเองทางด้านสุขภาพเป็นไปอย่างถูกหลักวิชาการ มีประสิทธิภาพ และปลอดภัย ซึ่งสำนักวิชาเภสัชศาสตร์ มหาวิทยาลัยวลัยลักษณ์ ได้ให้การสนับสนุน และบริการวิชาการในด้านที่เกี่ยวข้องอย่างสม่ำเสมอตลอดมา ซึ่งได้รับการเปิดเผยจาก ผู้ช่วยศาสตราจารย์ เภสัชกร ดร.บุญส่ง หวังสินทวีกุล ซึ่งเป็นที่ปรึกษาเกี่ยวกับโครงงานวิทยาศาสตร์ให้กับสถาบันการศึกษาทั้งใน และนอกมหาวิทยาลัยวลัยลักษณ์ว่า ประเด็นของความปลอดภัยของการใช้สมุนไพร มีการนำประเด็นนี้มาพิจารณา และศึกษาเพิ่มเติมมากขึ้น เพื่อเป็นแนวทางในการใช้สมุนไพรให้ถูกต้อง มีประสิทธิภาพ และปลอดภัย โดยเฉพาะการศึกษาถึงอันตรกิริยาของสมุนไพร และยาแผนปัจจุบันที่ผู้ป่วยอาจจะมีการใช้อยู่เดิม ซึ่งในช่วงปลายปี 2565 ทางสำนักวิชาเภสัชศาสตร์ ได้ให้บริการวิชาการแก่นักเรียนในโครงการ พสวท. แก่นักเรียน โรงเรียนเบญจมราชูทิศ นครศรีธรรมราช ในการศึกษา “ผลกระทบของสารสกัดจากใบกระท่อม (Mitragyna speciosa (Korth.) Havil.; Rubiaceae) บางสายพันธุ์ต่อการออกฤทธิ์ของยา Ampicillin Sodium ต่อเชื้อแบคทีเรียก่อโรค โดยมีนักเรียนที่ดำเนินการโครงการคือ นางสาวชุติกาญจน์ สุภัทรากุล และนางสาวศศิวิมล อารีกิจ ซึ่งผลงานดังกล่าวได้ดำเนินการเสร็จสิ้น โดยได้รับคำแนะนำเกี่ยวกับการคิด วิเคราะห์ และการทดลองทางด้านวิทยาศาสตร์ที่เกี่ยวข้อง ซึ่งผลงานดังกล่าวได้ รางวัลชนะเลิศ ระดับเหรียญทอง ในการนำเสนอผลงานทางวิชาการแบบบรรยาย ภาคภาษาไทย สาขาเคมี ในการประชุมวิชาการวิทยาศาสตร์ คณิตศาสตร์ และเทคโนโลยี ระดับชาติ ปีการศึกษา 2565 อีกด้วย ซึ่งทางสำนักวิชาเภสัชศาสตร์ ยังให้การสนับสนุนทางวิชาการในโรงเรียน และสถานศึกษาอื่น ๆ อีกอย่างต่อเนื่อง